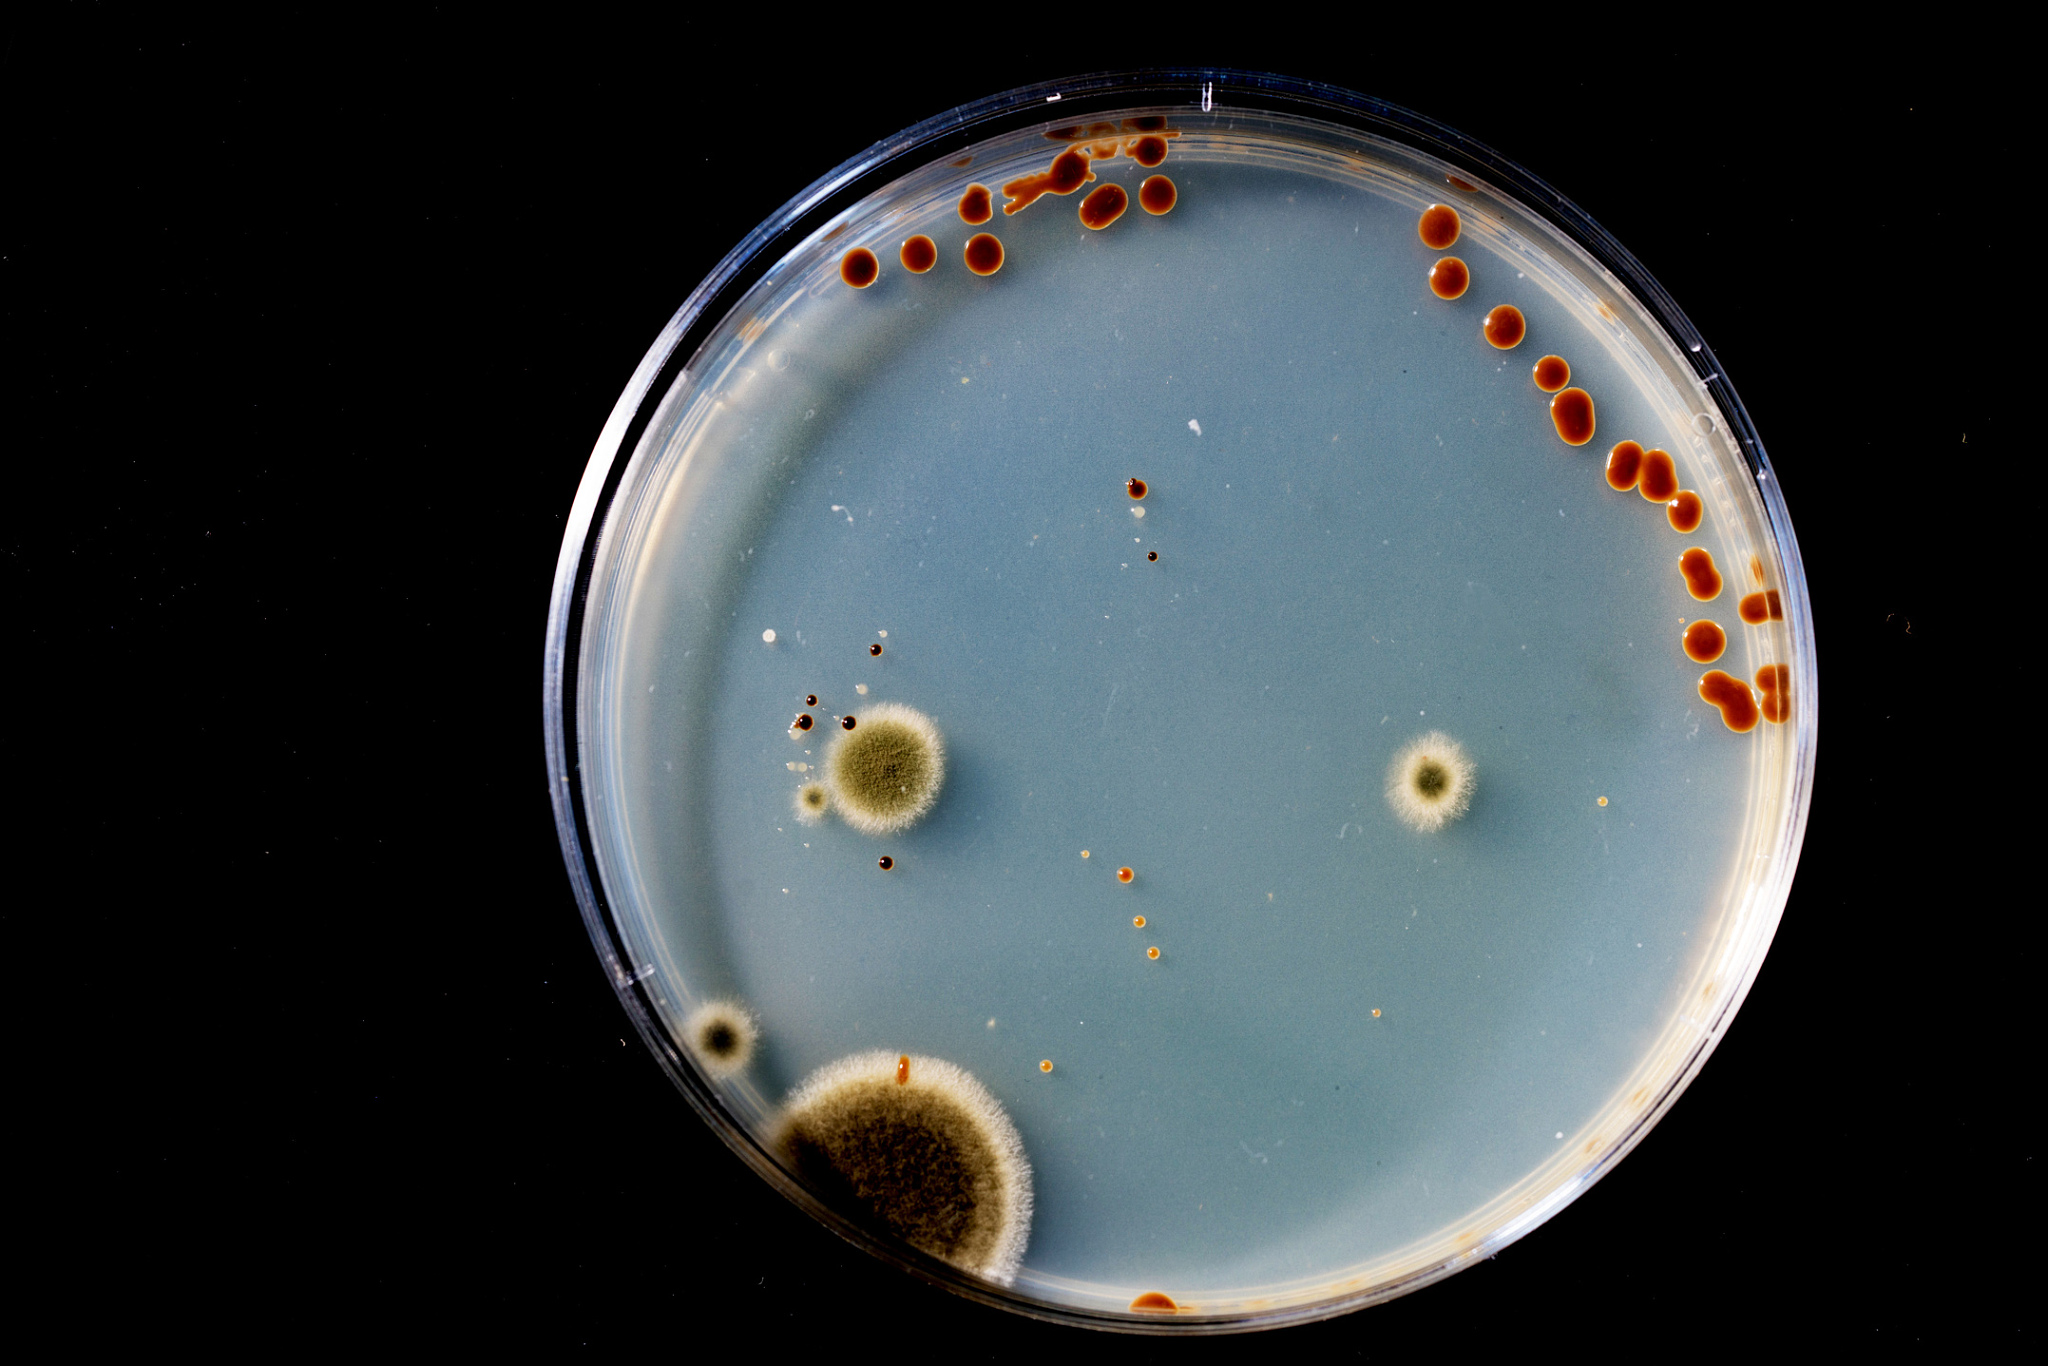
细胞培养污染来源详解：预防及控制

细胞培养污染来源详解:预防及控制
-
空气污染:细胞培养室内的空气中可能存在细菌、真菌、病毒等微生物。
-
水源污染:细胞培养用的水源可能存在细菌、真菌、病毒等微生物。
-
培养器具污染:培养器具如离心管、移液器、培养皿等可能存在微生物污染。
-
操作人员污染:操作人员可能存在细菌、病毒等微生物,通过手部、衣服等途径污染培养物。
-
培养基污染:培养基可能存在细菌、真菌、病毒等微生物,或者因为贮存不当、使用过期等原因导致污染。
-
培养物污染:培养物本身可能存在细菌、真菌、病毒等微生物,也可能因为污染源的存在而被污染。
原文地址: https://www.cveoy.top/t/topic/od7i 著作权归作者所有。请勿转载和采集!